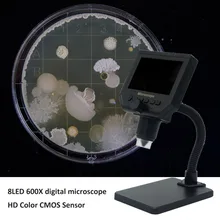
600X 8LED USB цифровой микроскоп Ручной Электронный Микроскоп с измерительной линейкой кронштейн 1000X цифровой Монокуляр Биологический Mi

Микроскопы
Откройте для себя уникальный выбор высококачественных товаров в категории "Микроскопы" на нашем сайте! Разнообразие и непревзойденное качество наших продуктов удивят вас. Тщательно подобранный ассортимент, отзывы клиентов и доступные цены гарантируют ваше удовлетворение. Следите за последними модными тенденциями, находите идеальные товары. Переходите к лучшим предложениям в категории "Микроскопы" и осуществите свои покупки уже сегодня! Страница 24